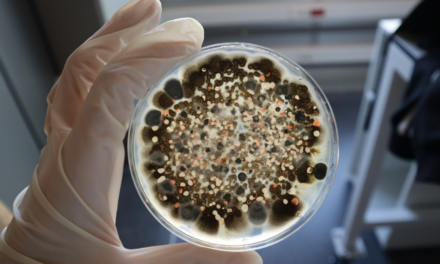
ValGenetics desarrollará la Plataforma Ecoefficacy para valorar la eficacia y modo de acción de productos bioestimulantes y agentes de biocontrol

Certis lanza un nuevo ebook sobre ácaros tetraníquidos

Los ácaros tetraníquidos son, en la actualidad, una de las principales plagas en frutales, cultivos hortícolas y cultivos extensivos, así como ornamentales
18.01.2022 – INFORMACIÓN
Los ácaros tetraníquidos son, en la actualidad, una de las principales plagas, por su capacidad para causar daños muy importantes en hojas, tallos y frutos de una amplia variedad de cultivos, en especial: frutales (como cítricos, melocotonero, manzano y vid), cultivos hortícolas (sobre todo tomate y pepino) y cultivos extensivos (como el algodón y el maíz), así como ornamentales.
Con el objetivo de ayudar a los agricultores a detectar, prevenir y controlar esta plaga, en Certis hemos elaborado un ebook sobre este tema, que amplía y complementa una guía anterior enfocada en la araña roja (Tetranychus urticae).
Una guía que aporta soluciones efectivas para combatir los ácaros tetraníquidos
En el ebook Ácaros tetraníquidos: cómo controlar y prevenir estos artrópodos encontrarás toda la información que necesitas para, en primer lugar, conocer en profundidad los principales tipos de ácaros tetraníquidos, su ciclo de vida y situaciones favorables para su desarrollo. Una vez diseccionadas en profundidad las características de este gran enemigo de los cultivos, se explican las herramientas y métodos con los que podemos hacer frente a esta complicada plaga.
A lo largo de esta guía, desarrollamos las medidas preventivas y los distintos productos de control y eliminación que ofrecemos en Certis, tanto convencionales como Bio-racionales.
Dentro del apartado de medidas de prevención, te explicamos los métodos más efectivos: potenciar e introducir depredadores naturales, eliminar restos de cultivos y la vigilancia continua y exhaustiva en los meses de mayor propagación (finales de verano y otoño).
Uno de los apartados más extensos y completos del ebook está dedicado a explicar las distintas soluciones de Certis para controlar y eliminar estos ácaros tan dañinos para muchos cultivos. Productos convencionales y Bio-racionales que con una combinación adecuada, aseguran una muy buena efectividad en el control de esta plaga.
Los acaricidas Nissorun® y Cesar® pertenecen al grupo químico de las tiazolidinacarboxamidas y actúan como reguladores del crecimiento frente a los principales tetraníquidos, logrando una eficaz acción ovicida y larvicida de gran eficacia. Award® es un acaricida formulado a base de Hexitiazox (3,12 %), en formato de suspensión concentrada, que resulta idóneo para el control de la araña roja en un amplio espectro de cultivos. Otro producto destacable es Dinamite®, cuyo innovador modo de acción clasificado por IRAC como 20B, actúa mediante el bloqueo de la cadena respiratoria de transferencia de electrones, uniéndose al centro UQ del Complejo III e impidiendo la producción de ATP en las mitocondrias del insecto
En lo que respecta a productos Bio-racionales aptos para agricultura ecológica específicos contra ácaros tetraníquidos, en el catálogo de Certis contamos con Botanigard® y Botanigard® 22 WP, insecticidas-acaricidas de origen biológico, ambos formulados a base de Beauveria bassiana cepa GHA, que actúan por contacto e infestación. Así como Majestik® insecticida/acarcida Bio-racional formulado a base de maltodextrina, registrado para el control de ácaros y mosca blanca en numerosos cultivos y Neudosan®, último producto en incorporarse al catálogo de productos Bio-racionales de Certis, formulado a base de sales de potasio de ácidos grasos insaturados C7-C18 y C18 de origen vegetal. Registrado para el control de pulgón, mosca blanca y araña en cultivos hortícolas de invernadero.
Descarga el ebook para aprender a controlar esta plaga:
Noticias relacionadas
Certis lanza una guía sobre sus productos Bio-racionales en cultivos hortícolas
https://ppt.tecnologiahorticola.com/plagas-cultivos-horticolas-sostenibilidad/